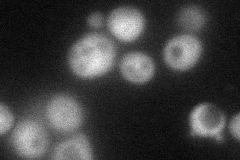
YLL018C-A
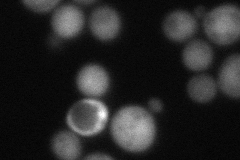
YLL018C-A
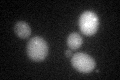
YLL018C-A
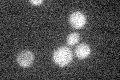
YLL018C-A

View description
Protein required for cytochrome c oxidase assembly, located in the cytosol and mitochondrial intermembrane space; putative copper metallochaperone that delivers copper to cytochrome c oxidase; contains twin cysteine-x9-cysteine motifs
Localization:
Intensity:
Fold change:
Significance:
-
C’ GFP library in SD

cytosol52.45 -
N' NOP1pr-GFP in SD
cytosol60.8636 -
N' TEF2pr-mCherry in SD
cytosol52.1743 -
N' NATIVEpr-GFP in SD

missing0 -
N' TEF2pr-VC and Cyto-VN in SD

#N/A0 -
C’ GFP library in SD+DTT
cytosol31.020.59Yes -
C’ GFP library in SD+H2O2

cytosol44.030.83No -
C’ GFP library in Starvation Media
cytosol18.660.35No -
C’ GFP library on the background of Pup2-DaMP

cytosol -
C’ GFP library on the background of CCT mutant

cytosol43.91020.837126No
